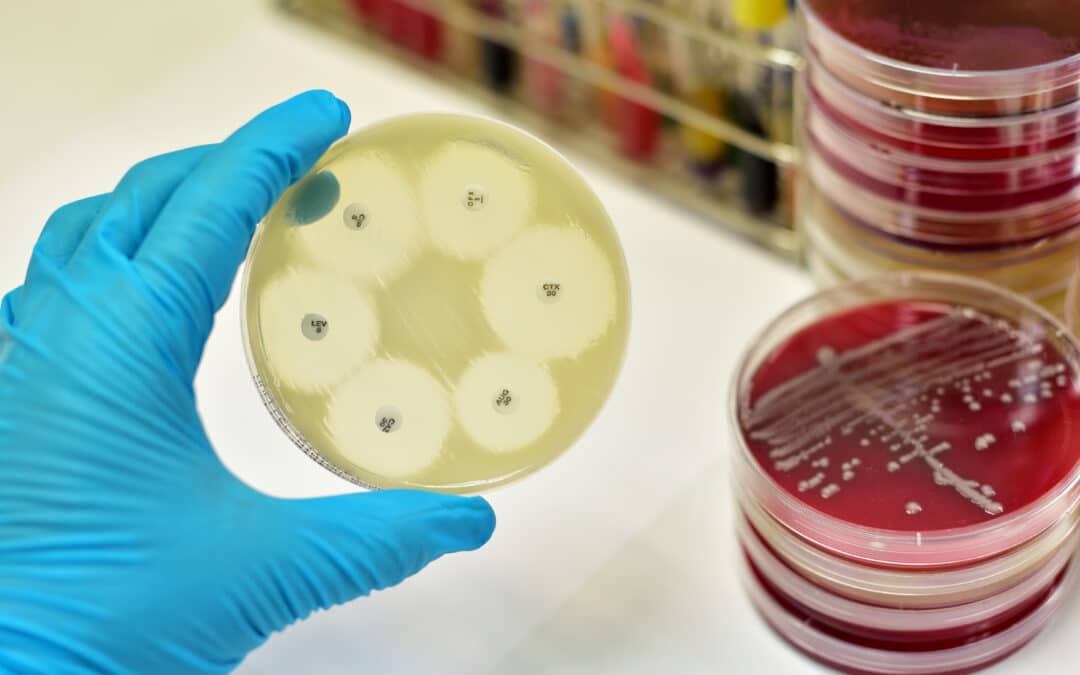
EPHA Newsletter | AMR in focus: addressing antimicrobial resistance in von der Leyen’s second term

by European Public Health Alliance | Jul 24, 2024 | Newsletters
Von der Leyen’s second term as President of the Commission has been confirmed with a vote in the European Parliament. Despite the initial years of her first mandate being overwhelmingly about health as the COVID19 pandemic swept the globe, there is now very...

by European Public Health Alliance | Jul 4, 2024 | Newsletters
EPHA’s Health Equity Feed brings you the latest news, events, and research on health equity in Europe and beyond. The forth health equity newsfeed of 2024 explores critical insights into health inequities across Europe, examining how systemic biases influence health...

by European Public Health Alliance | Jun 25, 2024 | Newsletters
The recent EU elections, which took place on 6-9 June, represent a pivotal moment for Europe. Citizens were called to the ballot box to uphold European democracy and express what matters to them. Ahead of the elections, EPHA and its members, along with a multitude of...

by European Public Health Alliance | May 23, 2024 | Newsletters
In the ongoing battle against non-communicable diseases (NCDs), confronting the commercial determinants that adversely affect public health remains a significant challenge. These determinants are largely fuelled by industries that profit from products linked to NCDs...

by European Public Health Alliance | May 7, 2024 | Newsletters
EPHA has launched its newest position paper on the question of the health and care workforce challenges, and ways forward to address those. The paper sets out the public health civil society’s position on the most important challenging points and bottlenecks, and...

by European Public Health Alliance | Apr 29, 2024 | Newsletters
EPHA’s Health Equity Feed brings you the latest news, events, and research on health equity in Europe and beyond. The third health equity newsfeed of the year features global and EU developments in sexual and reproductive health and rights (SRHR), a topic which also...